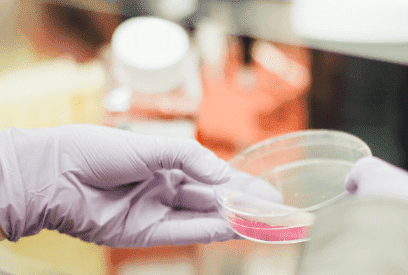
Cogit oraz ITP S.A. rozpoczynają wdrożenie rozwiązania do analiz zarządczych, controllingu i budżetowania

8 listopada 2019
Wdrożony system ma wspierać dynamiczny rozwój firmy i idący za tym wzrost potrzeb informacyjnych. W ramach projektu zostanie zbudowane rozwiązanie usprawniające proces budżetowania, raportowania i analizy, a także wesprze konsolidację finansową grupy.
Czytaj więcej (1 min)
24 października 2019
W dniu 23 października podczas Oracle Modern Business Summit, Cogit został wyróżniony tytułem Partnera roku 2019 firmy Oracle. Nagroda została przyznana ze szczególnym uwzględnieniem wkładu w rozwój kompetencji w obszarze EPM Cloud.
Czytaj więcej (1 min)
14 października 2019
Już niebawem, bo 23. października w Warszawie, odbędzie się Oracle Modern Business Summit. Jest to kolejne spotkanie z cieszącej się popularnością serii wydarzeń, organizowanych w wielu krajach Europy przez naszego Partnera. Zapraszamy do udziału.
Czytaj więcej (1 min)
7 października 2019
Cogit oraz Authority Software rozpoczęły współpracę w zakresie wsparcia raportowania zgodnego z jednolitym standardem sprawozdawczym ESEF.
Czytaj więcej (2 min)
25 września 2019
Zobacz rozwiązanie zaprojektowane przez finansistów dla finansistów. Rozwiązanie, które pomoże Ci dostosować firmę do wymogów raportowych zgodnych z ESEF. Nie czekaj na ostatnią chwilę. Podczas webinarium zaprezentujemy aplikację naszego partnera Authority Software i jej atuty.
Czytaj więcej (2 min)
11 września 2019
Cogit i Operator Chmury Krajowej rozpoczęły współpracę w obszarze usług Business Intelligence, rozwiązań dla controllingu i konsolidacji finansowej świadczonych za pośrednictwem infrastruktury Chmury Krajowej.
Czytaj więcej (2 min)
27 maja 2019
Co zrobić, żeby ułatwić sobie zarządzanie cash flow? Bazując na rozwiązaniu Infor d/EPM, pokażemy jak prosto, wykorzystując gotowe modele finansowe, jesteśmy w stanie automatycznie (do pewnego stopnia) obsłużyć raportowanie, analizowanie i planowanie przepływów finansowych.
Czytaj więcej (2 min)
26 kwietnia 2019
W dniach 23-24 maja 2019 w Warszawie odbędzie się 5. edycja Forum Informacji Zarządczej. Tym razem motywem przewodnim będą dane i ich kluczowe znaczenie dla funkcjonowania przedsiębiorstwa. Zapraszamy na nasze wystąpienie pierwszego dnia Forum, opowiemy o analityce w trybie self-service, czyli o tworzeniu analiz w kulturze data-driven.
Czytaj więcej (1 min)
1 kwietnia 2019
Już 27 kwietnia 2019 w ponad 300 lokalizacjach na całym Świecie odbędzie się Global Azure Bootcamp 2019. Zapraszamy do Krakowa, gdzie Hubert Kobierzewski zaprezentuje Azure Data Studio, czyli nowe wielosystemowe narzędzie do pracy z usługami przechowującymi i przetwarzającymi dane. Pokaże zarówno możliwości, jak i jeszcze istniejące ograniczenia.
Czytaj więcej (2 min)
25 lutego 2019
Zobacz jak dodawać nowe informacje z wykorzystaniem funkcji w Power BI. W większości przypadków nasze systemy nie dostarczą nam danych potrzebnych do wygenerowania interesującego nas raportu i konieczne jest tworzenie dodatkowych wyliczeń, przekształceń. Podczas webinarium skupimy się na kwestii wzbogacania danych źródłowych i pracy z Power Query w obszarze raportowania.
Czytaj więcej (2 min)
30 stycznia 2019
Hubert Kobierzewski podczas rozmowy z Łukaszem Kobylińskim ze Stacja.IT opowiada, o tym czym jest Business Intelligence - o wyzwaniach, problemach i korzyściach jakie może przynieść organizacji dobrze wdrożony BI. Posłuchaj podcastu.
Czytaj więcej (1 min)
17 stycznia 2019
Wzrost szybkości planowania, wyeliminowanie błędów związanych z wykorzystaniem Excela, łatwiejsze wprowadzanie zmian oraz ich natychmiastowa wizualizacja, to tylko wybrane elementy, które przyczyniły się do usprawnienia procesu planowania sprzedaży oraz dystrybucji nowych gier.
Czytaj więcej (2 min)